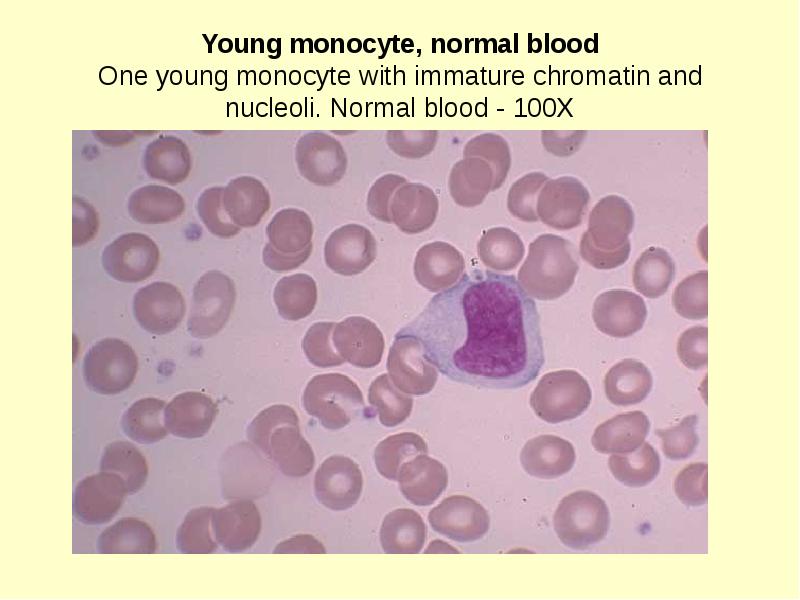

Fat immature with out of this world pointer
Hairy Bussy
Sucks Big Dick
Siri Strapon
Big White Ass Galleries
Touched bobis fingers pussy
Toons Sex Games
Wet Pussy Spreading
Dildo Chair Story
Brianna Banks Pussy Lick
Fat wife interracial xxx Black Male
Jay DeeBackstage of 'Make it Double!' Scene
Malaysian sex vivian-xxx pics
Shesfreay
Fat immature with out of this world pointer 113 photos